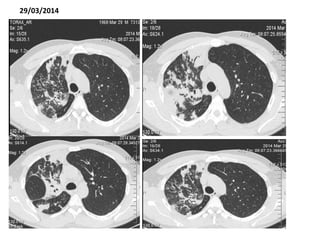
29/03/2014

Este paciente masculino de 48 años consultó por fiebre y tos de 6 meses de evolución. Exámenes revelaron una posible tuberculosis pulmonar con cavitación y antecedente de tratamiento incompleto. Fue hospitalizado y tratado con antibióticos y terapia antituberculosa. Sus síntomas y exámenes mejoraron y fue dado de alta para continuar el tratamiento de manera ambulatoria.